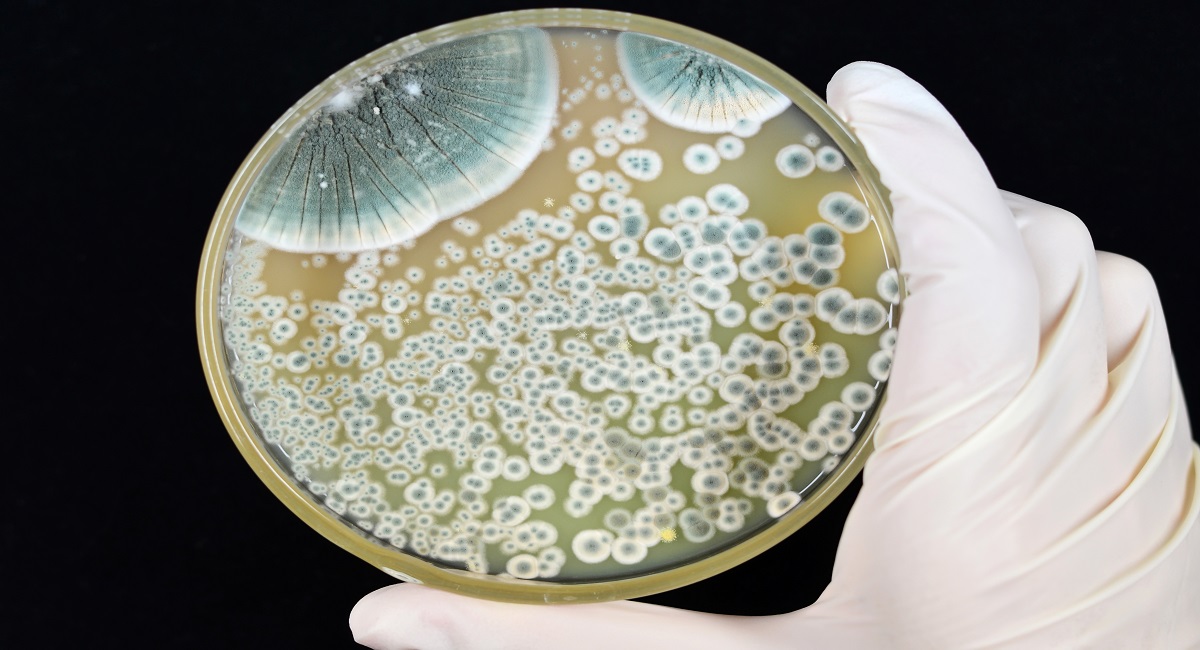

Колонии пенициллина: Взгляд в микромир

Раздел: Природная галерея